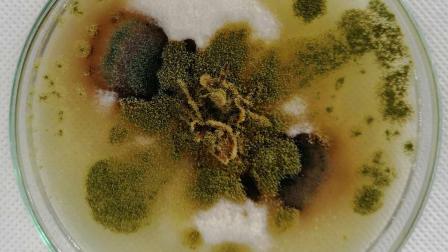
thumb

Estudia IPN bacterias que afectan al sistema endócrino
El proyecto se realiza en el Centro de Investigación en Biotecnología Aplicada Tlaxcala, bajo la dirección de Diana Verónica Cortés Espinosa
CIUDAD DE MÉXICO
Científicos del Instituto Politécnico Nacional (IPN) evalúan ciertas bacterias, hongos y/o levaduras para la degradación en suelos de Bisfenol A (BFA), que son contaminantes sintéticos que pueden causar daños a la salud al afectar el sistema endócrino, pues ingresan al organismo a través de los alimentos o bebidas, que se liberan en procesos térmicos en contenedores plásticos.
IPN se suma a disculpa pública por feminicidio de Yessenia
Al respecto, el secretario de Educación Pública, Esteban Moctezuma Barragán, ha mencionado que la educación de calidad es compromiso de la Nueva Escuela Mexicana para impulsar la formación de profesionistas con responsabilidad social, aptos para desarrollar investigaciones en beneficio de los mexicanos.
Desarrolla IPN sistema para edificios y ciudades inteligentes
El proyecto se realiza en el Centro de Investigación en Biotecnología Aplicada (CIBA) Tlaxcala, bajo la dirección de la doctora Diana Verónica Cortés Espinosa, quien señaló que el BFA también se puede encontrar en el medioambiente como remanente del proceso de elaboración de productos plásticos -ya que se utiliza como agente polimerizante-, además de liberarse durante su proceso de descomposición en rellenos sanitarios, contaminando agua, suelos y sedimentos.
La integrante del Sistema Nacional de Investigadores (SNI) Nivel I explicó que como parte de la innovación tecnológica desarrollaron dos metodologías para la conservación y aplicación de estos consorcios como sistemas de biorremediación de suelos contaminados, para ello se utilizó la técnica de inmovilización en diferentes matrices, una de ellas en polímeros naturales, donde los microorganismos se liberan paulatinamente en el suelo.
IPN dará $400 mensuales a estudiantes para Internet
La otra técnica consiste en la inmovilización en residuos agroindustriales, los cuales además de dar soporte para el crecimiento de los microorganismos son una fuente alternativa de carbono para realizar sus funciones metabólicas y activar las enzimas necesarias para la degradación de los contaminantes, además le dan porosidad al suelo, lo cual permite la aireación y facilita la disgregación de las partículas del suelo.
La experta en biotecnología ambiental destacó que mediante pruebas de almacenamiento comprobaron que los consorcios microbianos inmovilizados se mantienen latentes hasta por 22 meses y al ponerlos en condiciones adecuadas de temperatura, proveerles los nutrientes y humedad requeridos, se han logrado obtener mayores tasas de degradación de compuestos tóxicos en suelo. Por las propiedades descritas se está trabajando para obtener el registro de patente.
asc
EL EDITOR RECOMIENDA